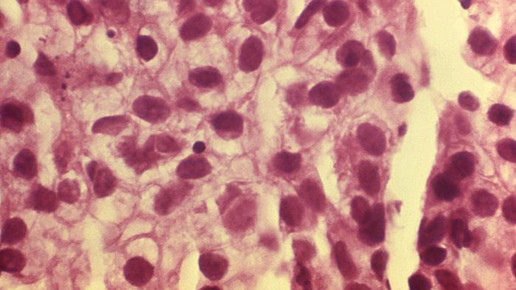
cancer krebs CDC a elizabeth plott CT ASCP

Hautkrebsrisiko unter HCT
Hautkrebs unter Hydrochlorothiazid (HCT): Das Thiazid-Diuretikum ist bekannt für seine Photosensibilisierung der Haut. Ein aktueller Rote-Hand-Brief informiert über das Risiko von nicht-melanozytärem Hautkrebs (NMSC), Plattenepithelkarzinom der Haut. Bereits im Juni hatten dänische Wissenschaftler einen Zusammenhang zwischen dem Arzneimittel und Karzinomen festgestellt und publiziert.
Ein erhöhtes Risiko für die Entstehung von Basalzell- und Plattenepithelkarzinomen unter HCT geht mit einer steigenden kumulativen Arzneimitteldosis einher. Hautveränderungen sind sowohl bei einer Einnahme von Mono- als auch Kombinationspräparaten möglich. Als möglicher Mechanismus für die Entstehung von Hautkrebs wird die photosensible Wirkung von HCT diskutiert. Die Fachinformation und Packungsbeilagen werden entsprechend aktualisiert.
Patienten sollten über die unerwünschte Arzneimittelwirkung informiert werden und ihre Haut regelmäßig auf neue Veränderungen oder jene an bestehenden Läsionen untersuchen lassen. Verdächtige Hautveränderungen sollen gemeldet und untersucht werden. Dabei sind histologische Untersuchungen von Biopsien vorzunehmen. Meldungen des Verdachtes einer Nebenwirkung sind für die kontinuierliche Überwachung des Nutzen-Risiko-Verhältnisses unerlässlich.
Unter HCT sollten ausgedehnte Sonnenbäder vermieden werden. Die Patienten sollten die Exposition gegenüber Sonnenlicht und UV-Strahlen reduzieren. Ein angemessener Sonnenschutz soll bei Sonnenexposition das Hautkrebsrisiko minimieren. Bereits an NMSC erkrankte Patienten sollten nur nach sorgfältigem Abwägen mit dem Thiazid-Diuretikum behandelt werden.
Der Ausschuss Pharmakovigilanz (PRAC) der Europäischen Arzneimittelagentur (EMA) hat die verfügbaren Datenquellen – zwei pharmakoepidemiologische Studien – ausgewertet. Die Studien basieren auf dänischen nationalen Datenquellen. Die Studienpopulation schloss etwa 71.500 Patienten mit BCC und mehr als 8600 Patienten mit SCC ein. Die Forscher konnten einen Zusammenhang zwischen dem Risiko für die Entstehung der Karzinome und der HCT-Dosis herstellen. So nimmt das Risiko mit höherer Dosis zu.
Patienten, die mit 50 mg HCT behandelt werden, haben ein um 1,29-fach erhöhtes Risiko an BCC zu erkranken. Für SCC erhöht sich das Risiko um das etwa Vierfache. Die Gefahr steigt mit einer Dosiserhöhung. Werden mindestens 200 mg HCT eingenommen, liegt das Risiko für BCC um das etwa 1,5-Fache beziehungsweise für SCC um das etwa Siebenfache höher. Der Anteil der Studienpopulation, die unter HCT ein BCC entwickelte, liegt bei 0,6 Prozent und für SCC bei 9 Prozent.
Die Tumore waren vor allem an sonnenexponierten Haustellen, insbesondere der unteren Gliedmaßen lokalisiert. Die Forscher konnten keinen Zusammenhang zwischen der Entstehung von weißem Hautkrebs und anderen Diuretika oder Blutdrucksenkern ermitteln. So gibt es kein erhöhtes Risiko unter Calciumkanal-Blockern, Furosemid, Indapamid, Nifedipin, Angitensin-II-Rezeptorantagonisten oder ACE-Hemmern.
Die zweite Studie mit einer Population von etwa 63.000 Personen zeigte unter HCT bei 633 Patienten einen möglichen Zusammenhang zu Lippenkrebs (SCC). Auch hier steigt das Risiko mit zunehmender HCT-Menge.

APOTHEKE ADHOC Debatte